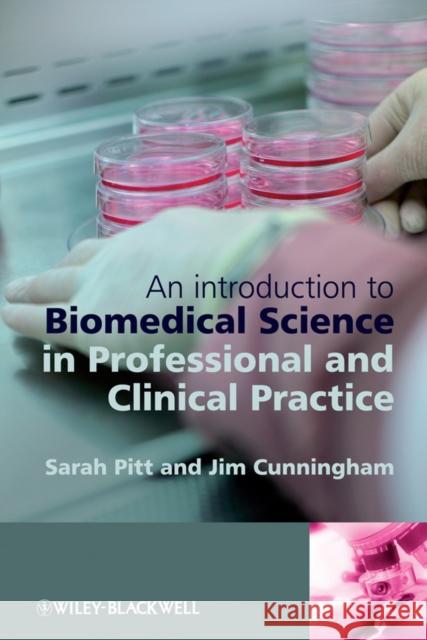
An Introduction to Biomedical Science in Professional and Clinical Practice Jim (University Of Brighton) Cunningham 9780470057155 0

» książki » Medical - Pathology
 |
Neurovascular Medicine Pursuing Cellular Longevity for Healthy Aging
ISBN: 9780195326697 / Angielski / Twarda / 592 str. Termin realizacji zamówienia: ok. 5-8 dni roboczych. Disorders of the nervous and vascular systems continue to burden the planet's population not only with increasing morbidity and mortality, but also with a significant financial drain through increasing medical care costs coupled to a progressive loss in economic productivity. For example, more than 500 million individuals suffer from nervous and vascular system disorders in the world that comprise both acute and chronic degenerative diseases such as hypertension, cardiac insufficiency, diabetes mellitus, stroke, traumatic brain injury, and Alzheimer's disease. Given the vulnerability of the...
Disorders of the nervous and vascular systems continue to burden the planet's population not only with increasing morbidity and mortality, but also wi...
|
cena:
1200,40 |
 |
Biopsy Pathology in Colorectal Disease, 2ed
ISBN: 9780340759226 / Angielski / Twarda / 400 str. Termin realizacji zamówienia: ok. 5-8 dni roboczych. Biopsy Pathology in Colorectal Disease shows how the practising pathologist can extract the maximum of diagnostic value from biopsies of the colon, rectum and anus. With the advances in colonoscopic mucosal biopsy techniques these are amongst the most frequently encountered specimens in hospital histopathology departments. This new edition provides practising pathologists and those in allied disciplines with a thorough guide to the diagnosis of colorectal conditions, both common and rare, and offers expert guidance in the handling of biopsy specimens. The most valuable information for...
Biopsy Pathology in Colorectal Disease shows how the practising pathologist can extract the maximum of diagnostic value from biopsies of the colon, re...
|
cena:
1018,05 |
 |
Biopsy Pathology of the Endometrium, 2ed
ISBN: 9780340807064 / Angielski / Twarda / 272 str. Termin realizacji zamówienia: ok. 5-8 dni roboczych. Now in its second edition, this book remains a vital reference manual for those pathologists whose work involves them in the interpretation of endometrial biopsies. A full account is given of the appearances of the endometrium during the menstrual cycle, of the effects of hormones, the changes induced by steroid contraceptives and intrauterine devices, of functional disorders and of inflammatory disease. Particular attention is given to the various forms of hyperplasia and neoplasia, with special emphasis being placed upon the differential diagnosis of these conditions. Other chapters deal...
Now in its second edition, this book remains a vital reference manual for those pathologists whose work involves them in the interpretation of endomet...
|
cena:
1066,53 |
 |
Pathology of Melanocytic Disorders 2ed
ISBN: 9780340809686 / Angielski / Twarda / 496 str. Termin realizacji zamówienia: ok. 5-8 dni roboczych. Formerly a highly regarded title in the Biopsy Pathology series, this book aims to be the gold standard work on the pathology of melanocytic disorders, while also functioning as a bench book. It covers the field comprehensively, including clinical data and photographs, as well as covering the basic mechanisms of pathogenesis in an introductory chapter. The main content of the book consists of the differential diagnosis of biopsy appearances, accompanied by high quality photographs to illustrate salient diagnostic features. As in the first edition, the text is supplemented by tables of...
Formerly a highly regarded title in the Biopsy Pathology series, this book aims to be the gold standard work on the pathology of melanocytic disorders...
|
cena:
1793,70 |
 |
Pathology in Clinical Practice: 50 Case Studies
ISBN: 9780340959046 / Angielski / Miękka / 224 str. Termin realizacji zamówienia: ok. 5-8 dni roboczych. So you've learnt the principles behind basic pathology and the mechanisms of disease; now consolidate your knowledge by putting those principles into clinical practice. here are fifty structured clinical scenarios to help you do so. Each case is based on a clinical situation that pulls together the key pathological, radiological and clinical aspects of a condition, while the questions and answers highlight diagnostic avenues and provide an attractive way of learning. Set your own level of challenge and build your clinical understanding by delving into a cluster of cases covering related...
So you've learnt the principles behind basic pathology and the mechanisms of disease; now consolidate your knowledge by putting those principles into ...
|
cena:
218,11 |
|
An Introduction to Biomedical Science in Professional and Clinical Practice
ISBN: 9780470057155 / Angielski / Miękka / 240 str. Termin realizacji zamówienia: ok. 5-8 dni roboczych. Biomedical Science in Professional and Clinical Practice is essential reading for all trainee biomedical scientists looking for an introduction to the biomedical science profession whether they are undergraduates following an accredited biomedical sciences BSc, graduate trainees or experienced staff with overseas qualifications. This book guides trainees through the subjects, which they need to understand to meet the standards required by the Health Professions Council for state registration. These include professional topics, laws and guidelines governing clinical pathology, basic...
Biomedical Science in Professional and Clinical Practice is essential reading for all trainee biomedical scientists looking for an introduction...
|
cena:
203,87 |
 |
Uterine Pathology
ISBN: 9780521509800 / Angielski / Twarda / 362 str. Termin realizacji zamówienia: ok. 5-8 dni roboczych. Part of the Cambridge Illustrated Surgical Pathology series, this book provides a comprehensive account of the experienced gynecologic pathologists' diagnostic approach to uterine pathology. Discussion is built around major pathologic entities in the uterus and cervix while highlighting the diverse and complex spectrum of alterations encountered in daily practice. Emphasizing clear description, diagnostic algorithms and problem solving, the book's primary goal is to lay the foundation for diagnostic accuracy, reproducibility, and relevance. It also dispels common misconceptions and encourages...
Part of the Cambridge Illustrated Surgical Pathology series, this book provides a comprehensive account of the experienced gynecologic pathologists' d...
|
cena:
589,58 |
 |
Breast Cytohistology with DVD-ROM
ISBN: 9780521515535 / Angielski / Twarda / 224 str. Termin realizacji zamówienia: ok. 5-8 dni roboczych. Comprehensive coverage of surgical pathology and cytopathology of breast lesions, with example vignettes and over 200 photomicrographs.
Comprehensive coverage of surgical pathology and cytopathology of breast lesions, with example vignettes and over 200 photomicrographs.
|
cena:
506,91 |
 |
lung and mediastinum cytohistology
ISBN: 9780521516587 / Angielski / Twarda / 290 str. Termin realizacji zamówienia: ok. 5-8 dni roboczych. Each volume in this richly illustrated series, sponsored by the Papanicolaou Society of Cytopathology, provides an organ-based approach to the cytological and histological diagnosis of small tissue samples. Benign, pre-malignant and malignant entities are presented in a well-organized and standardized format, with high-resolution color photomicrographs, tables, tabulated specific morphologic criteria and appropriate ancillary testing algorithms. Example vignettes allow the reader to assimilate the diagnostic principles in a case-based format. This volume provides comprehensive coverage of...
Each volume in this richly illustrated series, sponsored by the Papanicolaou Society of Cytopathology, provides an organ-based approach to the cytolog...
|
cena:
525,27 |
 |
Sudden Death in the Young
ISBN: 9780521516617 / Angielski / Twarda / 700 str. Termin realizacji zamówienia: ok. 5-8 dni roboczych. Determining the cause of death in children and young adults can pose considerable challenges. Professor Byard provides for the first time a complete overview of pathological aspects of sudden death in the young, from before birth to middle adult life. Highly illustrated with more than 800 colour figures, this third edition contains new sections on sexual abuse, pregnancy-related deaths and rare natural diseases, as well as expanded coverage of unexpected death in young adults up to the age of 30 years. Chapters are organised by systems and cover all aspects of natural death, as well as...
Determining the cause of death in children and young adults can pose considerable challenges. Professor Byard provides for the first time a complete o...
|
cena:
1407,07 |
 |
modern surgical neuropathology
ISBN: 9780521869324 / Angielski / Twarda / 532 str. Termin realizacji zamówienia: ok. 5-8 dni roboczych. The nervous system constitutes arguably the most complex organ system in the human body, which contributes to the over-susceptibility of disease in this area. Although brain tumors were once an automatic death sentence, the outlook for recovery has brightened significantly in the past decade. The pathologist plays an indispensable role in surgical diagnosis; he or she must accurately diagnose a potentially wide array of disease entities, determine the spread of disease within millimeters, and assess patient prognosis. This new and modern reference in neuropathology comprehensively covers all...
The nervous system constitutes arguably the most complex organ system in the human body, which contributes to the over-susceptibility of disease in th...
|
cena:
961,58 |
 |
lymph nodes
ISBN: 9780521871617 / Angielski / Twarda / 312 str. Termin realizacji zamówienia: ok. 5-8 dni roboczych. This text-atlas is a practical, integrated, and modern approach to lymph node pathology. Intended for both practicing pathologists and pathologists in training, it provides a personal view of lymph node diagnosis by one of the international leaders in the field. Illustrated with over 250 full-color photographs, this book covers the entire range of disease that may be encountered in lymph node pathology. It features extensive coverage of non-neoplastic lymphoid lesions and non-lymphoid lesions, as well as discussing all malignant lymphomas and other neoplasms that may involve lymph nodes in...
This text-atlas is a practical, integrated, and modern approach to lymph node pathology. Intended for both practicing pathologists and pathologists in...
|
cena:
791,65 |
![Orell & Sterrett's Fine Needle Aspiration Cytology [With Access Code] Orell & Sterrett's Fine Needle Aspiration Cytology [With Access Code] Orell, Svante R. 9780702031519 0](/9780702031519_orell__sterretts_fine_needle_aspiration_cytology_with_access_code.jpg) |
Orell & Sterrett's Fine Needle Aspiration Cytology [With Access Code]
ISBN: 9780702031519 / Angielski / Twarda / 512 str. Termin realizacji zamówienia: ok. 5-8 dni roboczych. Orell & Sterrett's Fine Needle Aspiration Cytology 5e provides you with a logical and systematic approach to the acquisition, interpretation and diagnosis of FNA biopsy samples. It is an ideal resource for all those requiring an authoritative and systematic review of the cytological findings in those malignant and benign lesions likely to be the target of FNA. The book is lavishly illustrated with high quality colour images that demonstrate the cytological features as well as their relevant immunohistochemical and molecular findings. Organized into anatomical regions, each chapter is... Orell & Sterrett's Fine Needle Aspiration Cytology 5e provides you with a logical and systematic approach to the acquisition, interpretation and di... |
cena:
1114,95 |
 |
Lewin, Weinstein and Riddell's Gastrointestinal Pathology and Its Clinical Implications
ISBN: 9780781722162 / Angielski / Twarda / 1712 str. Termin realizacji zamówienia: ok. 5-8 dni roboczych. Lewin Gastrointestinal Pathology and Its Clinical Implications, Second Edition Lewin Gastrointestinal Pathology and Its Clinical Implications, Second Edition |
cena:
1730,63 |
 |
musculoskeletal cytohistology hardback
ISBN: 9781107014053 / Angielski / Twarda / 326 str. Termin realizacji zamówienia: ok. 5-8 dni roboczych. Describes the cytologic, small core biopsy, immunohistochemical and molecular diagnostic features of musculoskeletal lesions, with numerous images and clinical vignettes.
Describes the cytologic, small core biopsy, immunohistochemical and molecular diagnostic features of musculoskeletal lesions, with numerous images and...
|
cena:
506,91 |
 |
Extranodal Lymphomas: Expert Consult - Online and Print
ISBN: 9781416045793 / Angielski / Twarda / 432 str. Termin realizacji zamówienia: ok. 5-8 dni roboczych. Extranodal Lymphomas is a practical, easy-to-use guide that helps you accurately diagnose even the most challenging cases. Dr. Judith Ferry and leaders in the field present their expertise to fill the need for a highly-illustrated, authoritative reference that keeps you up to date on histologic, immunophenotypic, genetic, and clinical features, along with risk factors and current nomenclature. This comprehensive resource also features access to the fully searchable text and a downloadable image library online at www.expertconsult.com so you'll have convenient access to everything you need... Extranodal Lymphomas is a practical, easy-to-use guide that helps you accurately diagnose even the most challenging cases. Dr. Judith Ferry and lea... |
cena:
688,39 |
 |
Current Concepts in Gynecologic Pathology: Epithelial Tumors of the Gynecologic Tract, an Issue of Surgical Pathology Clinics: Volume 4-1
ISBN: 9781437722659 / Angielski / Twarda / 504 str. Termin realizacji zamówienia: ok. 5-8 dni roboczych. This new series for surgical pathologists presents -current concepts- in pathology diagnosis, key features, differential diagnosis, overview, pitfalls, and molecular approaches for every disease entity and body region. This publication on gynecologic epithelial tumors includes topics on Clinical approach to diagnosis and management of tumors of the cervis and vulva; Biomarkers in cervical cancer diagnosis; Pathology of vulvar neoplasms; Clinical approach to diagnosis and management of the corpus; Molecular overview of cancer of the corpus; Complex atypical hyperplasia and differentiated...
This new series for surgical pathologists presents -current concepts- in pathology diagnosis, key features, differential diagnosis, overview, pitfalls...
|
cena:
184,17 |
 |
Prenatal Screening and Diagnosis, an Issue of Clinics in Laboratory Medicine: Volume 30-3
ISBN: 9781437724622 / Angielski / Twarda / 253 str. Termin realizacji zamówienia: ok. 5-8 dni roboczych. This issue of Clinics in Laboratory Medicine, Guest Edited by Anthony Odibo and David Krantz, will feature article topics such as: Screening for Chromosomal abnormalities; Cystic fibrosis screening; The role of second-trimester screening, in the post-first trimester screening era; Modifying risk for Aneuploidy with second-trimester ultrasound after a positive serum screen; Cost-effectiveness of Down syndrome screening paradigms; Biochemical and biophysical screening for the risk of Preterm delivery; Pre-implantation genetic diagnosis; Prenatal testing for infectious disease, Thrombophilias,...
This issue of Clinics in Laboratory Medicine, Guest Edited by Anthony Odibo and David Krantz, will feature article topics such as: Screening for Chrom...
|
cena:
305,36 |
 |
Systems Biology in the Clinical Laboratory, an Issue of Clinics in Laboratory Medicine: Volume 31-2
ISBN: 9781437724639 / Angielski / Twarda / 370 str. Termin realizacji zamówienia: ok. 5-8 dni roboczych. This issue of Clinics in Laboratory Medicine, Guest Edited by Zoltan Oltvai, MD, will focus on Conceptual Advances in Pathology. The issue will discuss the convergence of anatomic pathology, clinical pathology and genomics and other sciences, with the technological underpinning of digital pathology. Topics will include: CAD in digital pathology and Modeling protein motion. This issue of Clinics in Laboratory Medicine, Guest Edited by Zoltan Oltvai, MD, will focus on Conceptual Advances in Pathology. The issue will dis... |
cena:
305,36 |
 |
Thyroid Cytopathology
ISBN: 9781441959522 / Angielski / Miękka / 200 str. Termin realizacji zamówienia: ok. 5-8 dni roboczych. The evaluation of thyroid nodules by fine needle aspiration (FNA) is one of the most challenging tasks in all of cytopathology. A cytologist must understand the clinical presentation of thyroid diseases, their defining histopathologic and cytopathologic features, and even the intricacies of patient management. Drs. Clark and Faquin have provided a valuable framework for cytologists learning (and continuing to learn) this exacting discipline. Org- ized around a practical algorithm, the authors lay out a rational and concise approach toward acquiring the necessary skills for the cytologic...
The evaluation of thyroid nodules by fine needle aspiration (FNA) is one of the most challenging tasks in all of cytopathology. A cytologist must unde...
|
cena:
562,23 |













